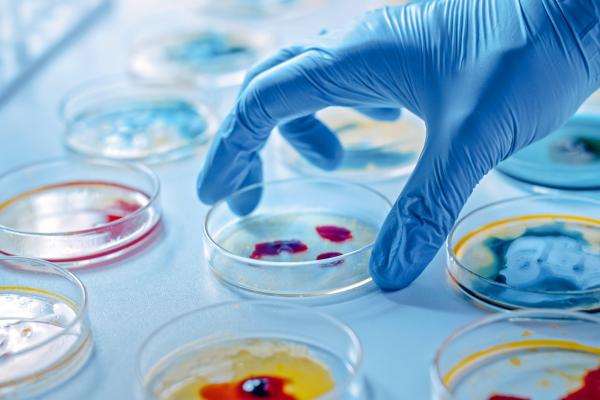

Más información
Historia
El VHIR nació con el objetivo de promover la investigación y apoyar a los investigadores del Hospital Universitario Vall d'Hebron. A lo largo de estos más de 30 años, hemos conseguido el liderazgo en investigación biomédica hospitalaria en nuestro país. Hoy se nos reconoce como instituto de investigación europeo excelente, competitivo y líder en investigación clínica y traslacional vinculado a un hospital universitario.
El Vall d'Hebron Instituto de Investigación es un centro reconocido internacionalmente por la excelencia de su investigación. Desde el año 2009 cuenta con la Acreditación ISCIII otorgada por el Instituto de Salud Carlos III. También se ha visto reconocido en Sistemas de Gestión de la Calidad y de la Innovación, por la excelencia en recursos humanos o de la calidad de la enseñanza universitaria, entre otros.
Temáticas en las que se especializa
Hacemos investigación para solucionar los problemas de salud de las personas. Nuestra tarea no es solo básica o traslacional; somos líderes en investigación clínica. Tenemos las camas del hospital a menos de 50 metros de los laboratorios y nuestros pacientes se benefician de la investigación que llevamos a cabo. Creemos en esto, por eso nos esforzamos. También lo entienden así los líderes de la industria, que apuestan por nuestro hospital a la hora de realizar sus primeros ensayos clínicos, convirtiéndonos de este modo en un referente mundial.
Sobre el centro
Somos una institución del sector público que promueve y desarrolla la investigación, la innovación y la docencia biosanitaria del Hospital Universitario Vall d'Hebron, el hospital terciario de alta tecnología más grande de entre los gestionados por el Instituto Catalán de la Salud (ICS), situado en Barcelona.
Somos líderes en investigación clínica y la industria farmacéutica apuesta por nuestro hospital a la hora de realizar sus primeros ensayos clínicos, convirtiéndolo de esta manera en un referente mundial.
Cursos destacados

-
El curso de Gestión Administrativa de Ensayos Clínicos ofrece un buen punto de partida, con contenidos claros y fáciles de seguir. La metodología es práctica.
← | →
-
El contenido ha sido interesante y relevante.
Me ha parecido un ritmo adecuado, una cantidad asumible de contenido en el tiempo indicado.
Las preguntas reflejaban bien el contenido del tema.
El primer webinar no fue muy informativo pero el resto estuvo muy bien.
Sobre todo el webinar que eran preguntas con Iñaki, me sirvió mucho para aclarar conceptos y poder entender por qué eran incorrectas algunas respuestas.
← | →
-
Sin estos profesionales, estaríamos indefensos en la lucha en favor de la salud. Intento apuntarme a los cursos del centro cuando puedo.
← | →
- Curso
- Online
- Nivel avanzado
- 15 sept 2026
- 2 Meses
¿Quieres impulsar tu carrera en el sector de la investigación clínica? Conviértete en un experto en la gestión administrativa de ensayos, dominando la presentación de estudios ante el CEIm y autoridades competentes, el apoyo integral al equipo investigador y a los CRAs, y la gestión de trámites críticos en centros hospitalarios. A través de este programa, adquirirás competencias...
¿Quieres impulsar tu carrera en el sector de la investigación clínica? Conviértete en un experto en la gestión administrativa de ensayos, dominando la presentación de estudios ante el CEIm y autoridades competentes, el apoyo integral al equipo investigador y a los CRAs, y la gestión de trámites críticos en centros hospitalarios. A través de este programa, adquirirás competencias...
-
El curso de Gestión Administrativa de Ensayos Clínicos ofrece un buen punto de partida, con contenidos claros y fáciles de seguir. La metodología es práctica.
← | → ver todas
-
El contenido ha sido interesante y relevante.
Me ha parecido un ritmo adecuado, una cantidad asumible de contenido en el tiempo indicado.
Las preguntas reflejaban bien el contenido del tema.
El primer webinar no fue muy informativo pero el resto estuvo muy bien.
Sobre todo el webinar que eran preguntas con Iñaki, me sirvió mucho para aclarar conceptos y poder entender por qué eran incorrectas algunas respuestas.
← | → ver todas
-
Sin estos profesionales, estaríamos indefensos en la lucha en favor de la salud. Intento apuntarme a los cursos del centro cuando puedo.
← | → ver todas

- Curso
- Barcelona
- Part time
- 30 mar 2027
- 2 Meses
The aim of the specialization course in Self leadership and soft skills is to reinforce interpersonal skills to lead effectively, with a team management perspective and adequate communication skills.

- Curso
- Barcelona
- Part time
- Nivel avanzado
- 27 abr 2027
- 2 Meses
The main goal of the specialization course Spin-off and start-up companies creation is to provide knowledge, tools and skills to have a comprehensive strategic vision and to know all the necessary elements to create a competitive technology-based company.

-
Esta muy bien para los estudiantes
← | →
- Master
- Barcelona
- 28 sept 2026
- 10 Meses
Are you ready too drive health innovation? Become a specialist in health innovation by mastering clinical research methodologies, strategic project management, and the implementation of medical technologies. Throughout this master’s program, you will develop essential competencies in regulatory frameworks, digital health integration, healthcare business models, and collaborative...
Are you ready too drive health innovation? Become a specialist in health innovation by mastering clinical research methodologies, strategic project management, and the implementation of medical technologies. Throughout this master’s program, you will develop essential competencies in regulatory frameworks, digital health integration, healthcare business models, and collaborative...
-
Esta muy bien para los estudiantes
← | →

- Curso
- Barcelona
- Part time
- 29 oct 2026
- 3 Meses
The aim of the specialization course Innovation strategies, models, and methodologies in Health is to explore the perpetual innovation in the evolution of healthcare, in which strategic methodologies are used to pave the way for a transformative change. This course offers an opportunity to navigate the intersection of innovation and high-value healthcare, unravelling a...

- Curso
- Barcelona
- Part time
- 26 ene 2027
- 2 Meses
The main goal of the specialization course Valorization and technology transfer is to provide the knowledge and skills needed to devise and develop a health innovation project in terms of technology, clinical development, business model and regulatory strategy. As well as having a strategic vision to define the best strategy for transferring technology to the market.
Opiniones sobre Vall d'Hebron Institut de Recerca (14)
Opiniones
Valoración del Centro
Lo recomiendan
Gestión Administrativa de Ensayos Clínicos (CTA)
Alba Mir Cros
Gestión Administrativa de Ensayos Clínicos (CTA)
Alejandra García Blanco
Master in Health Innovation and Entrepreneurship
Carolina Moritz Rodriguez
Gestión Administrativa de Ensayos Clínicos (CTA)
Marcel
Gestión Administrativa de Ensayos Clínicos (CTA)
Sofia M. del Rio
Gestión Administrativa de Ensayos Clínicos (CTA)
Patricia Dávila Manrique
Gestión Administrativa de Ensayos Clínicos (CTA)
anna casas cubells
Gestión Administrativa de Ensayos Clínicos (CTA)
José Manuel Alonso
Gestión Administrativa de Ensayos Clínicos (CTA)
Ester Mateos Mullor
Gestión Administrativa de Ensayos Clínicos (CTA)
Brenno Dominguez
Gestión Administrativa de Ensayos Clínicos (CTA)
Aitor Rodríguez Martínez
Gestión Administrativa de Ensayos Clínicos (CTA)
Diego García
Gestión Administrativa de Ensayos Clínicos (CTA)
Koen Galenkamp
Gestión Administrativa de Ensayos Clínicos (CTA)
Miguel Ángel C. E. (Miguel)
Dónde está
- Barcelona Pg. de la Vall d'Hebron 129
Equipo Docente
Anna Sala
Head of Innovation Unit in Hospital Vall d' Hebron
Iñaki Díaz de Junguitu
Research Projects Evaluator (CEIm) en VHIR
Inma Fuentes Camps
Directora de Core Facilities at Vall d’Hebron Institute of Research (V
Josep Ramos Ramos-Quiroga
Head of Department of Mental Health en Hospital Universitari Vall Hebr
María Garrido
Senior Innovation Manager and Tech Transfer

Mireia Navarro
Responsable USCE (Unidad de Soporte a los Comités de Ética)- Vall d'He
Nunzio Cifariello
Strategy & Alliance Innovation Manager
Rafael Navajo
Innovation and Business Development Director at Vall d'Hebron Research

Santiago Pérez-Hoyos
Cap d'Unitat d'Estadística i Bioinformàtica (UEB) Core Faciliti
¿Necesitas un coach de formación?
Te ayudará a comparar y elegir el mejor curso para ti y a financiar tu matrícula en cómodos plazos.